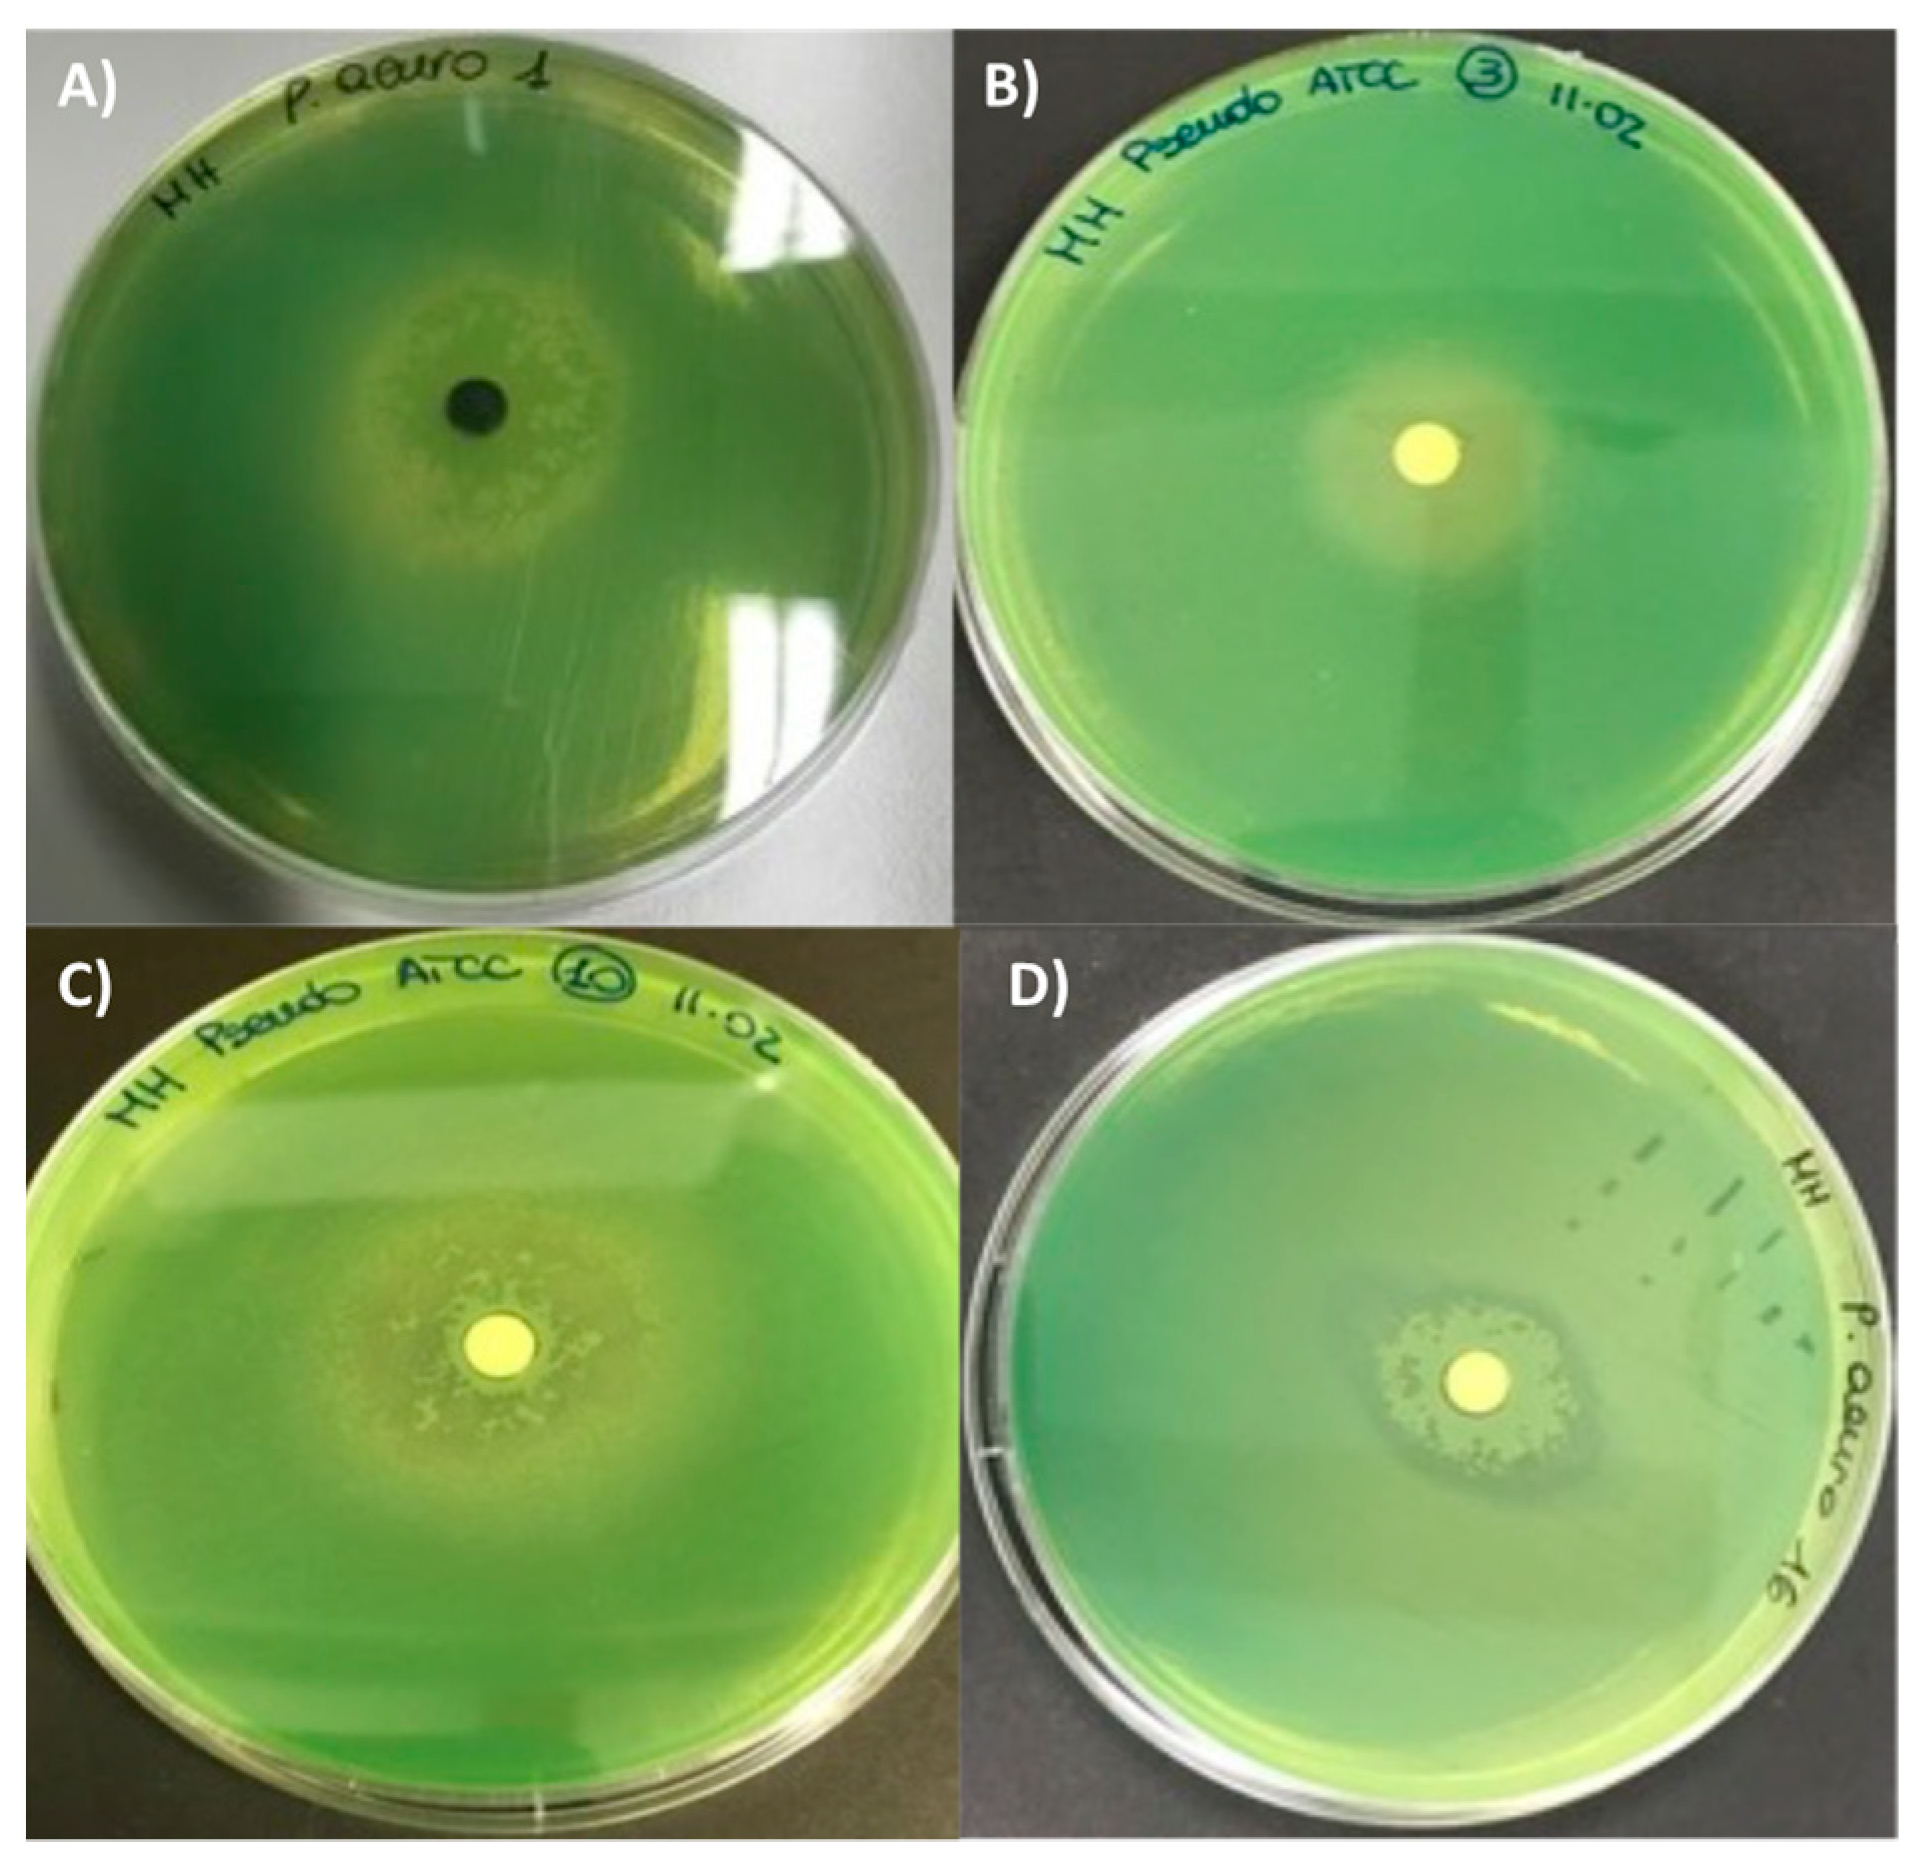
Antibiotics 10 01424 g003

A Systematic Study of the Antibacterial Activity of Basidiomycota Crude Extracts
Abstract
:1. Introduction
2. Results and Discussion
2.1. Taxonomic Classification
2.2. Biological Activity of Fruitbody Crude Extracts
3. Materials and Methods
3.1. Sampling and Taxonomic Classification
3.1.1. Fungal Material
3.1.2. DNA Fingerprinting
3.2. Extraction of Phytochemicals from Fruiting Bodies
3.3. Antifungal and Antibacterial Assays
3.3.1. Antifungal Assay
3.3.2. Antibacterial Assay
3.4. Siderophore Production
3.5. Statistical Analysis
4. Conclusions
Author Contributions
Funding
Data Availability Statement
Conflicts of Interest
References
- Fair, R.J.; Tor, Y. Antibiotics and Bacterial Resistance in the 21st Century. Perspect. Med. Chem. 2014, 6, 14459. [Google Scholar] [CrossRef] [Green Version]
- Sharma, D.; Misba, L.; Khan, A.U. Antibiotics versus Biofilm: An Emerging Battleground in Microbial Communities. Antimicrob. Resist. Infect. Control 2019, 8, 76. [Google Scholar] [CrossRef]
- Tacconelli, E.; Carrara, E.; Savoldi, A.; Harbarth, S.; Mendelson, M.; Monnet, D.L.; Pulcini, C.; Kahlmeter, G.; Kluytmans, J.; Carmeli, Y.; et al. Discovery, Research, and Development of New Antibiotics: The WHO Priority List of Antibiotic-Resistant Bacteria and Tuberculosis. Lancet Infect. Dis. 2018, 18, 318–327. [Google Scholar] [CrossRef]
- Santajit, S.; Indrawattana, N. Mechanisms of Antimicrobial Resistance in ESKAPE Pathogens. BioMed Res. Int. 2016, 2016, 2475067. [Google Scholar] [CrossRef] [PubMed] [Green Version]
- Zhen, X.; Lundborg, C.S.; Sun, X.; Hu, X.; Dong, H. Economic Burden of Antibiotic Resistance in ESKAPE Organisms: A Systematic Review. Antimicrob. Resist. Infect. Control 2019, 8, 137. [Google Scholar] [CrossRef] [PubMed] [Green Version]
- Benedict, K.; Jackson, B.R.; Chiller, T.; Beer, K.D. Estimation of Direct Healthcare Costs of Fungal Diseases in the United States. Clin. Infect. Dis. 2019, 68, 1791–1797. [Google Scholar] [CrossRef] [PubMed] [Green Version]
- Fasciana, T.; Cortegiani, A.; Ippolito, M.; Giarratano, A.; Di Quattro, O.; Lipari, D.; Graceffa, D.; Giammanco, A. Candida auris: An Overview of How to Screen, Detect, Test and Control This Emerging Pathogen. Antibiotics 2020, 9, 778. [Google Scholar] [CrossRef] [PubMed]
- Karwehl, S.; Stadler, M. Exploitation of Fungal Biodiversity for Discovery of Novel Antibiotics. In How to Overcome the Antibiotic Crisis; Current Topics in Microbiology and Immunology; Stadler, M., Dersch, P., Eds.; Springer International Publishing: Cham, Switzerland, 2016; Volume 398, pp. 303–338. ISBN 978-3-319-49282-7. [Google Scholar]
- Alves, M.; Ferreira, I.; Dias, J.; Teixeira, V.; Martins, A.; Pintado, M. A Review on Antimicrobial Activity of Mushroom (Basidiomycetes) Extracts and Isolated Compounds. Planta Med. 2012, 78, 1707–1718. [Google Scholar] [CrossRef] [Green Version]
- Klančnik, A.; Megušar, P.; Sterniša, M.; Jeršek, B.; Bucar, F.; Smole Možina, S.; Kos, J.; Sabotič, J. Aqueous Extracts of Wild Mushrooms Show Antimicrobial and Antiadhesion Activities against Bacteria and Fungi: Bioactivity of Aqueous Extracts of Wild Mushrooms. Phytother. Res. 2017, 31, 1971–1976. [Google Scholar] [CrossRef]
- Vallavan, V.; Krishnasamy, G.; Zin, N.M.; Abdul Latif, M. A Review on Antistaphylococcal Secondary Metabolites from Basidiomycetes. Molecules 2020, 25, 5848. [Google Scholar] [CrossRef] [PubMed]
- Suay, I.; Arenal, F.; Asensio, F.J.; Basilio, A.; Cabello, M.A.; Dıez, M.T.; Garcıa, J.B.; Gorrochategui, J.; Hernandez, P.; Pelaez, F.; et al. Screening of Basidiomycetes for Antimicrobial Activities. Antonie Leeuwenhoek 2000, 78, 129–140. [Google Scholar] [CrossRef]
- Keller, C.; Maillard, M.; Keller, J.; Hostettmann, K. Screening of European Fungi for Antibacterial, Antifungal, Larvicidal, Molluscicidal, Antioxidant and Free-Radical Scavenging Activities and Subsequent Isolation of Bioactive Compounds. Pharm. Biol. 2002, 40, 518–525. [Google Scholar] [CrossRef]
- Mavrodi, D.V.; Bonsall, R.F.; Delaney, S.M.; Soule, M.J.; Phillips, G.; Thomashow, L.S. Functional Analysis of Genes for Biosynthesis of Pyocyanin and Phenazine-1-Carboxamide from Pseudomonas aeruginosa PAO1. J. Bacteriol. 2001, 183, 6454–6465. [Google Scholar] [CrossRef] [PubMed] [Green Version]
- Gonçalves, T.; Vasconcelos, U. Colour Me Blue: The History and the Biotechnological Potential of Pyocyanin. Molecules 2021, 26, 927. [Google Scholar] [CrossRef] [PubMed]
- Salih, S.; Mohammed, L. Antibiotic Action of Pyocyanin on Some Pathogenic Bacteria Isolated from Wound Infection. Int. J. Adv. Res. IJAR 2017, 5, 1197–1201. [Google Scholar] [CrossRef] [Green Version]
- Cox, C.D. Role of Pyocyanin in the Acquisition of Iron from Transferrin. Infect. Immun. 1986, 52, 263–270. [Google Scholar] [CrossRef] [PubMed] [Green Version]
- Reszka, K.J.; O’Malley, Y.; McCormick, M.L.; Denning, G.M.; Britigan, B.E. Oxidation of Pyocyanin, a Cytotoxic Product from Pseudomonas aeruginosa, by Microperoxidase 11 and Hydrogen Peroxide. Free. Radic. Biol. Med. 2004, 36, 1448–1459. [Google Scholar] [CrossRef]
- Gill, M.; Steglich, W. Pigments of Fungi (Macromycetes). In Progress in the Chemistry of Organic Natural Products; Springer: Vienna, Austria, 1987. [Google Scholar]
- Gill, M.; Smrdel, A.F.; Strauch, R.J.; Begley, M.J. Pigments of Fungi. Part 12. Structure and Absolute Stereochemistry of Antibiotic Tetrahydroanthraquinones from the Fungus Dermocybe splendida Horak. X-ray Structure Determination of Austrocortirubin Phenylboronate and Austrocortilutein Acetonide. J. Chem. Soc. Perkin Trans. 1 Org. Bio.-Org. Chem. 1990, 1583–1592. [Google Scholar] [CrossRef]
- Beattie, K.D.; Rouf, R.; Gander, L.; May, T.W.; Ratkowsky, D.; Donner, C.D.; Gill, M.; Grice, I.D.; Tiralongo, E. Antibacterial Metabolites from Australian Macrofungi from the Genus Cortinarius. Phytochemistry 2010, 71, 948–955. [Google Scholar] [CrossRef] [PubMed]
- Daferner, M.; Anke, T.; Hellwig, V.; Steglich, W.; Sterner, O. Stobilurin M, Tetrachloropyrocatechol and Tetrachloropyrocatechol Methyl Ether: New Antibiotics from a Mycena Species. J. Antibiot. 1998, 51, 816–822. [Google Scholar] [CrossRef] [PubMed] [Green Version]
- Peters, S.; Spiteller, P. Sanguinones A and B, Blue Pyrroloquinoline Alkaloids from the Fruiting Bodies of the Mushroom Mycena sanguinolenta. J. Nat. Prod. 2007, 70, 1274–1277. [Google Scholar] [CrossRef] [PubMed]
- Lohmann, J.S.; Wagner, S.; von Nussbaum, M.; Pulte, A.; Steglich, W.; Spiteller, P. Mycenaflavin A, B, C, and D: Pyrroloquinoline Alkaloids from the Fruiting Bodies of the Mushroom Mycena haematopus. Chem. Eur. J. 2018, 24, 8609–8614. [Google Scholar] [CrossRef] [PubMed]
- Centko, R.M.; Ramón-García, S.; Taylor, T.; Patrick, B.O.; Thompson, C.J.; Miao, V.P.; Andersen, R.J. Ramariolides A–D, Antimycobacterial Butenolides Isolated from the Mushroom Ramaria cystidiophora. J. Nat. Prod. 2012, 75, 2178–2182. [Google Scholar] [CrossRef]
- Dovana, F.; Contu, M.; Angeli, P.; Brandi, A.; Mucciarelli, M. Leucoagaricus ariminensis Sp. Nov., a Lilac Species from Italy. Mycotaxon 2017, 132, 205–216. [Google Scholar] [CrossRef]
- Gardes, M.; Bruns, T.D. ITS Primers with Enhanced Specificity for Basidiomycetes Application to the Identification of Mycorrhizae and Rusts. Mol. Ecol. 1993, 2, 113–118. [Google Scholar] [CrossRef] [PubMed]
- White, T.J.; Bruns, T.; Lee, S.; Taylor, J. Amplification and Direct Sequencing of Fungal Ribosomal RNA Genes for Phylogenetics. In PCR Protocols; Elsevier: Amsterdam, The Netherlands, 1990; pp. 315–322. ISBN 978-0-12-372180-8. [Google Scholar]
- Kearse, M.; Moir, R.; Wilson, A.; Stones-Havas, S.; Cheung, M.; Sturrock, S.; Buxton, S.; Cooper, A.; Markowitz, S.; Duran, C.; et al. Geneious Basic: An Integrated and Extendable Desktop Software Platform for the Organization and Analysis of Sequence Data. Bioinformatics 2012, 28, 1647–1649. [Google Scholar] [CrossRef]
- Katoh, K. MAFFT: A Novel Method for Rapid Multiple Sequence Alignment Based on Fast Fourier Transform. Nucleic Acids Res. 2002, 30, 3059–3066. [Google Scholar] [CrossRef] [Green Version]
- Stamatakis, A. RAxML Version 8: A Tool for Phylogenetic Analysis and Post-Analysis of Large Phylogenies. Bioinformatics 2014, 30, 1312–1313. [Google Scholar] [CrossRef] [PubMed]
- De Bernardi, M.; Vidari, G.; Vita-Finzi, P.; Gluchoff-Fiasson, K. Biogenesis like Conversion of Marasmane to Lactarane and Seco-Lactarane Skeleton. Tetrahedron Lett. 1982, 23, 4623–4624. [Google Scholar] [CrossRef]
- Bona, E.; Cantamessa, S.; Pavan, M.; Novello, G.; Massa, N.; Rocchetti, A.; Berta, G.; Gamalero, E. Sensitivity of Candida albicans to Essential Oils: Are They an Alternative to Antifungal Agents? J. Appl. Microbiol. 2016, 121, 1530–1545. [Google Scholar] [CrossRef] [PubMed]
- Massa, N.; Cantamessa, S.; Novello, G.; Ranzato, E.; Martinotti, S.; Pavan, M.; Rocchetti, A.; Berta, G.; Gamalero, E.; Bona, E. Antifungal Activity of Essential Oils against Azole-Resistant and Azole-Susceptible Vaginal Candida glabrata Strains. Can. J. Microbiol. 2018, 64, 647–663. [Google Scholar] [CrossRef] [PubMed]
- Bona, E.; Arrais, A.; Gema, L.; Perotti, V.; Birti, B.; Massa, N.; Novello, G.; Gamalero, E. Chemical Composition and Antimycotic Activity of Six Essential Oils (Cumin, Fennel, Manuka, Sweet Orange, Cedar and Juniper) against Different Candida spp. Nat. Prod. Res. 2019, 35, 4600–4605. [Google Scholar] [CrossRef]
- Bona, E.; Massa, N.; Novello, G.; Pavan, M.; Rocchetti, A.; Berta, G.; Gamalero, E. Essential Oil Antibacterial Activity against Methicillin-Resistant and -Susceptible Staphylococcus aureus Strains. Microbiol. Res. 2019, 10, 31–38. [Google Scholar] [CrossRef] [Green Version]
- Schwyn, B.; Neilands, J. Universal Chemical Assay for the Detection and Determination of Siderophore. Anal. Biochem. 1987, 160, 47–56. [Google Scholar] [CrossRef]
- R Core Team. R: A Language and Environment for Statistical Computing; R Foundation for Statistical Computing: Vienna, Austria, 2018. [Google Scholar]

| Species Number * | Species | Sampling Site § |
|---|---|---|
| 1 | Cortinarius mussivus | B |
| 2 | Cortinarius caesiocanescens | A |
| 3 | Cortinarius variecolor | B |
| 4 | Cortinarius reverendissimus | A |
| 5 | Cortinarius percomis | A |
| 6 | Cortinarius nanceiensis | B |
| 7 | Cortinarius bovinus | B |
| 8 | Ramaria pallida | A |
| 9 | Ramaria parabotrytis | A |
| 10 | Ramaria pallidosaponaria | B |
| 11 | Ramaria flavescens | B |
| 12 | Leucocortinarius bulbiger | B |
| 13 | Gymnopus confluens | A |
| 14 | Hydnellum spongiosipes | C |
| 15 | Mycena renati | C |
| 16 | Mycena zephyrus | B |
Publisher’s Note: MDPI stays neutral with regard to jurisdictional claims in published maps and institutional affiliations. |
© 2021 by the authors. Licensee MDPI, Basel, Switzerland. This article is an open access article distributed under the terms and conditions of the Creative Commons Attribution (CC BY) license (https://creativecommons.org/licenses/by/4.0/).
Share and Cite
Clericuzio, M.; Bivona, M.; Gamalero, E.; Bona, E.; Novello, G.; Massa, N.; Dovana, F.; Marengo, E.; Robotti, E. A Systematic Study of the Antibacterial Activity of Basidiomycota Crude Extracts. Antibiotics 2021, 10, 1424. https://doi.org/10.3390/antibiotics10111424
Clericuzio M, Bivona M, Gamalero E, Bona E, Novello G, Massa N, Dovana F, Marengo E, Robotti E. A Systematic Study of the Antibacterial Activity of Basidiomycota Crude Extracts. Antibiotics. 2021; 10(11):1424. https://doi.org/10.3390/antibiotics10111424
Chicago/Turabian StyleClericuzio, Marco, Mattia Bivona, Elisa Gamalero, Elisa Bona, Giorgia Novello, Nadia Massa, Francesco Dovana, Emilio Marengo, and Elisa Robotti. 2021. "A Systematic Study of the Antibacterial Activity of Basidiomycota Crude Extracts" Antibiotics 10, no. 11: 1424. https://doi.org/10.3390/antibiotics10111424
APA StyleClericuzio, M., Bivona, M., Gamalero, E., Bona, E., Novello, G., Massa, N., Dovana, F., Marengo, E., & Robotti, E. (2021). A Systematic Study of the Antibacterial Activity of Basidiomycota Crude Extracts. Antibiotics, 10(11), 1424. https://doi.org/10.3390/antibiotics10111424

